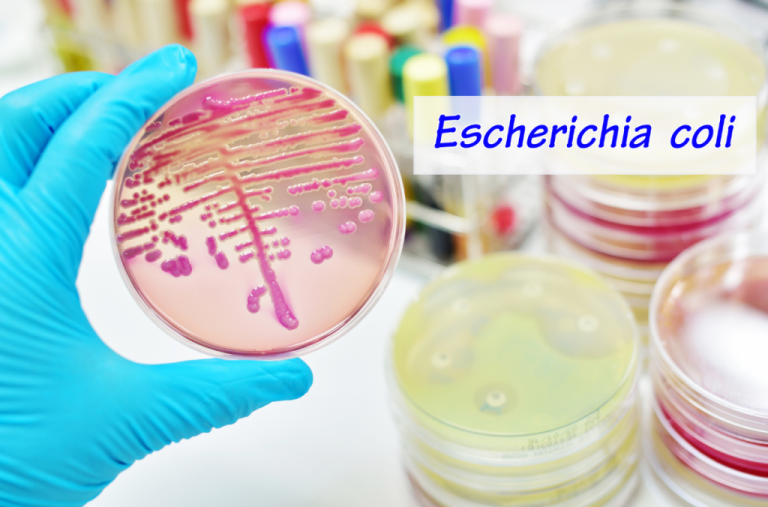
e. coli, kólibaktérium, kóli baktérium, kóli baktérium a vizeletben, escherichia coli, e coli baktérium kiírtása, coli baktériumok, e coli baktérium székletben, e coli fertőzés kezelése, escherichia coli baktérium, escherichia coli fertőzés, escherichia coli jelentése, e coli, coli baktérium, e coli baktérium kiírtása, e coli baktérium, coli e

Irritábilis bél szindróma (IBS)
Irritábilis bél szindróma esetén a betegnél különféle gyomor-bélrendszeri panaszok jelentkeznek. Hátterükben szervi okok nem mutatkoznak. Funkcionális emésztőrendszeri problémáról van szó.
Tartalomjegyzék

Mi is az az irritábilis bél szindróma (IBS)?
Az irritábilis bél szindróma (IBS) a gyomor-bél traktus egyik leggyakoribb funkcionális rendellenessége. Nemcsak a vastagbél érintett, hanem az emésztőrendszer teljes hossza. A súlyos emésztési problémák hátterében sokszor az alapos orvosi kivizsgálás következtében sem fedezhető fel szervi ok.
Becslések szerint a fejeltt államokban a lakosság körülbelül 20%-a szenved kisebb-nagyobb mértékben IBS-ben. A nők körülbelül kétszer olyan gyakran érintettek, mint a férfiak. A tünetek általában 20 és 30 éves kor között jelentkeznek először, és gyakran hónapokig vagy évekig tartanak. A bélfertőzéssel kapcsolatos antibiotikum-használat gyakran azonosítható kiváltó okként (ún. fertőzés utáni irritábilis bél szindróma). A betegek életminősége sok esetben jelentősen csökken.
Mik az irritábilis bél szindróma tünetei?
Az irritábilis bél szindróma tipikus tünetei a hasi fájdalom, görcsök, puffadás és székrekedés vagy hasmenés. A stressz is súlyosbítja a tüneteket, melyek székletürítés után néha enyhülnek, étkezés után azonban, ha az érintett túl sokat evett, gyakrabban jelentkeznek. Ilyenkor előfordulhat, hogy az emésztőenzimek mennyisége nem elegendő, rothadási és erjedési dyspepsia lép fel, ami pedig puffadást vált ki.
Olyan érzés, mintha a bél nem lenne képes megfelelően kiürülni. Gyomorégés, büfögés és bélhangok is előfordulhatnak. Csak más súlyos szervi betegségek kizárása után (a tünetek egyéb okait ki kell zárni) lehet az irritábilis bél szindróma diagnózist felállítani. Maga a betegség nagyon megterhelő, de nem veszélyes.


Panaszok irritábilis bél szindróma esetén
Az irritábilis bél szindróma (IBS) betegség akkor áll fenn, ha a következő 3 pont teljesül:
- Léteznek krónikus, azaz 3 hónapnál hosszabb ideig tartó panaszok (pl. hasi fájdalom, puffadás), melyek hátterében a beteg és az orvos a belek rendellenes működését feltételezi, és amelyeket általában a székletürítés változásai kísérnek (hasmenés, székrekedés vagy a hasmenés és a székrekedés váltakozása).
- A panaszok miatt a beteg segítséget kér és/vagy sokat aggódik, és a tünetek olyan súlyosak, hogy az életminőségre nagy hatással vannak.
- Előfeltétele, hogy ne álljanak fenn más klinikai képre jellemző elváltozások, amelyek ezekért a panaszokért felelősek.

Kísérő tünetek
Gyakran a következő problémák vagy panaszok társulnak az irritábilis bél szindrómához:
- Szorongásos zavarok
- Depresszió
- Álmatlanság
- Krónikus fáradtság szindróma (CFS)
- Fejfájás (migrén)
- Fibromyalgia
- Menstruációs görcsök
Irritábilis bél szindrómával a mindennapokban
Az IBS diagnózis felállítása után van néhány dolog, amire érdemes odafigyelni. Hallgasson a testére és ismerje fel, mely ételek tesznek jót, és melyek okoznak kellemetlenséget. Foglalkozzon a tünetekkel, így a kirándulások és a normális mindennapi élet ismét szórakoztató lesz, nem pedig terhes.

Az irritábilis bél szindróma kiváltó okai
Az irritábilis bél szindróma orvosi és tudományos okairól különböző elméletek léteznek. Az IBS kiváltó okai között feltételezik többek között a gyomor és a bélrendszer bakteriális fertőzéseit, az emésztőrendszer területén az immunrendszer működésének zavarát és a kóros bélperisztaltikát. A tudósok számos elváltozást tudtak azonosítani az érintettek beleiben. Ezek a változások azonban nemcsak irritábilis bél szindrómában, hanem krónikus gyulladásos bélbetegségek, divertikulitisz és ételintolerancia esetén is előfordulnak.
Az irritábilis bél szindrómával küzdőknél az étel túl gyorsan vagy túl lassan halad át az emésztőrendszeren. Az érintettek ezért hasmenéstől (amikor túl gyors az áthaladási ideje, így nem történik folyadékfelszívódás, a széklet híg marad) vagy székrekedéstől szenvedhetnek (amikor túl lassú az áthaladás). Gyakran előfordul, hogy a bél szabálytalanul népesedik be (ekkor az emésztést segítő bélbaktériumok kevesebben vannak, vagyis a káros, gázképző baktériumok kerülnek fölénybe), fokozottan képződik bélgáz, amelyek teltségérzethez, puffadáshoz és erős hasi fájdalomhoz vezetnek. Ezenkívül az irritábilis bél szindrómában szenvedők érzékenyebbek a fájdalomra, többek között azért, mert a nyújtási ingerekre csökkent fájdalomküszöbük. A káros anyagokkal szemben a védő bélgát meggyengül, a bélfal átjárhatóbbá válik (áteresztő bél szindróma): nem történik meg a káros anyagok megfelelő eltávolítása. A stressz súlyosbítja a tüneteket. Az irritábilis bél szindrómában szenvedő betegek fokozottan hajlamosak depresszióra és szorongásos zavarokra. A vegetatív idegrendszer diszfunkciója pszichoszomatikus zavarokkal együtt szintén szóba kerül.
Az irritábilis bél szindrómában szenvedőknél az étel túl gyorsan vagy túl lassan halad át az emésztőrendszeren. Az érintettek ezért szenvedhetnek hasmenéstől (a székletürítés ideje túl gyors, így nem történik meg a folyadék visszaszívódása, a széklet híg marad) vagy székrekedéstől (a székletürítés túl lassú). Gyakran előfordul, hogy a bél rosszul kolonizálódik (az emésztést segítő bélbaktériumok kevesebben vannak, a káros, gázképző baktériumok kerülnek fölénybe), valamint túlzott mennyiségű bélgáz képződik, ami teltségérzethez, puffadáshoz és erős hasi fájdalomhoz vezet. Továbbá az irritábilis bél szindrómával küzdő betegek fájdalomérzékenysége megnő, többek között azért, mert a nyújtási ingerekre csökken fájdalomküszöbük. A káros anyagokkal szemben védő bélbarrier meggyengül, a bélfal átjárhatóbbá válik (áteresztő bél szindróma). A káros anyagok megfelelő eltávolítása bizonyos mértékben sikertelen. A stressz súlyosbítja a tüneteket. Az irritábilis bél szindrómában szenvedő betegek fokozottan hajlamosak a depresszióra és a szorongásos zavarokra. A vegetatív idegrendszer működési zavarai mellett a pszichoszomatikus rendellenességek is szóba kerülnek.
További lehetséges kiváltó okok:
A szerotonin neurotranszmitter szintén felelős a fájdalomérzetért. Ha a bél idegrendszere irritábilis bél szindrómában ingerült, akkor már nem tudja megfelelően szabályozni, hogy mennyi hírvivő anyag szabadul fel. Így fordulhat elő, hogy az érintettek erősebben érzékelik a bélrendszerüket, és fájdalmat tapasztalnak, míg az „egészséges” embereknél ezek az ingerek nem lépik át az érzékelési küszöböt.
Az irritábilis bél szindróbával küzdők bélfala különösen érzékenyen reagál az ételekből származó nyújtási ingerekre. A bélnek saját idegrendszere van a bélfalban (enterális idegrendszer = ENS), amelyet „hasi agynak” is neveznek. Ez jelzi, amikor a táplálék a bélbe kerül, és megnyújtja a falat. Az ENS a szerotonin neurotranszmitterrel együtt úgy irányítja az emésztést, hogy a bélizmokat váltakozó összehúzódásra és elernyedésre serkenti, perisztaltikus hullámot hozva létre, és előre szállítva a táplálékot. Az irritábilis bél szindrómában ez a bélrendszeri idegrendszer zavart, „irritált”, ezért hibás utasításokat ad a bélizmoknak. Ez szinkronizálatlan bélmozgásokat eredményez, ami az emésztés egészét is rontja. Vagy a táplálékpép túl gyorsan szállítódik, így hasmenés alakul ki (hasmenéses irritábilis bél szindróma). Az ellenkezője is lehetséges: ha az izmok túl lassan mozognak, székrekedés alakulhat ki (székrekedés irritábilis bél szindróma). Az irritábilis bélgörcsök és a puffadás akkor jelentkezik, ha az izmok túlságosan összehúzódnak, és már nem lazulnak el teljesen.
Számos tanulmány kimutatta, hogy az irritábilis bél szindróma gyomor-bélrendszeri fertőzések („gyomor influenza”) következménye lehet. Lehetséges, hogy bizonyos baktériumokkal (például Campylobacter jejuni, Clostridum difficile, káros E.coli) való bélfertőzések nagyobb valószínűséggel váltanak ki irritábilis bél szindrómát, mint más kórokozók. Enterális (= a beleket érintő) fertőzés csak minden tizedik esetért felelős. Ha bélfertőzés okozza az irritábilis bél szindrómát, az embereknél jellemzően kifejezett hasmenéses tünetek jelentkeznek. Az antibiotikumok, amelyeket gyakran idő előtt alkalmaznak bélfertőzés kezelésére, szintén károsítják a bél biotópját, és irritábilis bél szindróma kiváltó okai lehetnek.
Az érintettek bélnyálkahártyájának szövetmintáiban kimutatható a fokozott immunaktivitás. Így a nyálkahártyán kimutatható az immunrendszer védekező sejtjei és azok hírvivő anyagainak jelenléte (pl. interleukinok). Hogy honnan ered ez a fokozott aktivitás az irritábilis bél szindrómában, és mit szolgálhat, még kutatják.
A bélnyálkahártyában a szomszédos sejtek egy-egy szoros kötésen keresztül kapcsolódnak egymáshoz. Ezek zárják le a sejteket egymás ellen, hogy a sejtek között ne tudjanak idegen anyagok vagy kórokozók átjutni. Amíg ez a bél barrier ép, a bélnyálkahártya sejtjeinek összessége valóságos védőpajzsot képez, amely megakadályozza, hogy idegen anyagok jussanak be a szervezetbe a bélrendszerből. Az irritábilis bél szindrómában ez a bélgát „lyukas”, a sejtek már nem kapcsolódnak olyan szorosan egymáshoz, így a kórokozók és a toxinok könnyebben behatolhatnak a bélnyálkahártyába, és immunreakcióhoz, irritációhoz vezethetnek.

Hogyan ismerhető fel az irritábilis bél szindróma?
Az irritábilis bél szindróma diagnózisa a panaszok jellegzetessége alapján és más klinikai képek kizárása után állítható fel.
- Hol és milyen helyzetben jelentkezik a fájdalom?
- Hasmenése vagy székrekedése van?
- Tapasztalt-e összefüggést a fájdalom és bizonyos ételek vagy italok fogyasztása között?
- Vannak-e egyéb tünetek, például hányás, izomfájdalom, ízületi fájdalom, gyomorégés vagy láz? Észlelt-e vért a székletében? Hamar elfárad? Fogyott az utóbbi időben? Előbbiek az irritábilis bél szindróma esetén nem jellemzőek, és más súlyos betegségek riasztó jelének számítanak.
- Stresszes élete van?
- Egyéb más betegséget állapítottak meg Önnél? Vizsgálja meg a kiváltó okokat és körülményeket (pl. stressz, düh, túlhajszoltság), melyek a tüneteket is súlyosbíthatják.
- Szed-e rendszeresen, vagy szedett-e az elmúlt hetekben gyógyszert (pl. antibiotikumot, fájdalomcsillapítót, szívgyógyszert, pajzsmirigygyógyszert, hashajtót)?
- Családi anamnézisre vonatkozó kérdések (betegségek jelenléte a családban)
- Szerves bélbetegségek (pl. súlyos hasmenéssel járó krónikus gyulladásos bélbetegség)
Minden diagnózis felállítása elején részletes anamnézisfelvételre kerül sor az orvossal.
Vizsgálatok az irritábilis bél szindróma diagnosztizálására
A megbeszélés után az orvos megvizsgálja a beteget, ekkor megnézi a végbélnyílást, valamint megtapogatja és meghallgatja a hasüreget. A székletminta információt ad az emésztési rendellenességekről és a bélrendszer működési zavarairól. A székletet rejtett vér miatt is megvizsgálják. Az orvos a bélrendszer mellett a húgyhólyagot, a veséket, nőknél a petefészkeket és tünetektől függően a szívet is ellenőrzi.
A vér és a széklet elemzése (vér a székletben, paraziták (férgek), a vizelet, valamint a szervek vizsgálata szintén fontos információkkal szolgálnak. A puffadáshoz hasonlóan ki kell zárni az olyan ételintoleranciákat, mint a fruktóz-, laktóz-, szorbit- stb. intolerancia. Ha a tünetek hevenyek, súlycsökkenéssel, lázzal, fáradékonysággal, vérszegénységgel, hányással, ízületi panaszokkal vagy véres széklettel járnak, akkor súlyos betegségeket okozhatnak, az alapbetegség további orvosi tisztázása feltétlenül szükséges. Meg kell vizsgálni a máj, az epehólyag vagy a hasnyálmirigy betegségeinek jeleit.

Ezt követheti a végbél és a vastagbél vizsgálata (kolonoszkópia). A vastagbéltükrözés során a vastagbél és a vékonybél végét vizsgálják endoszkóposan a végbélcsatornán keresztül. A belek kontrasztanyaggal készült röntgenfelvételen is láthatók. Ha szervi betegség, ételintolerancia vagy krónikus gyulladásos bélbetegség kizárható, az orvos irritábilis bél szindrómát állapít meg. Az irritábilis bél szindróma egy „kizárásos diagnózis”, amelyet csak akkor lehet felállítani, ha egyéb más kiváltó ok biztosan nem áll fenn.
Egyéb lehetséges diagnosztikai intézkedések:
- A hasüreg ultrahangos vizsgálata (szonográfia)
- A bél és a has röntgenvizsgálata, ma már többnyire komputertomográfia (CT) formájában
Mi segít az irritábilis bél szindróma esetén?
A legújabb kutatások azt mutatják, hogy az IBS enyhe (krónikus) gyulladással és kevésbé változatos vagy működőképes bélflórával is összefügg. Az irritábilis bél szindróma gyakran fordul elő bélfertőzések után, különösen akkor, ha ezeket antibiotikumokkal kezelik, ugyanis a gyógyszerek a természetes, egészséges bélflórát is károsítják, melynek következtében kórokozó baktériumok továbbterjedhetnek. Ennek eredményeként a bélrendszer, vagyis a védőgát egyre „áteresztőbbé” válik. A mirha, a kamilla és a kávészén szigetelő hatással bír a belekben.

Hogyan kezelhető az irritábilis bél szindróma?
Az irritábilis bél szindróma kellemetlen betegség, amely nagyban befolyásolja az életminőséget. Kezelés csak korlátozott mértékben lehetséges és tünetorientált. A legfontosabb, hogy mindenekelőtt a panaszait be tudja sorolni, és ne kelljen attól tartania, hogy komoly betegség áll a háttérben. Mivel a hagyományos gyógyszerek mellékhatásai gyakran súlyosak lehetnek, fontos mérlegelni, hogy a gyógyszeres kezelés kockázatai nem magasabbak-e, mint maguk a tünetek.
Az étrend megváltoztatása és a puffasztó és nehezen emészthető ételek kerülése gyakran enyhítheti a tüneteket. A természetes gyógymódok elegendőek lehetnek az enyhe tünetek kizárólagos kezelésére, de a hagyományos orvosi kezelést is támogathatják.
A borsmentaolaj gyomorsavnak ellenálló formában, amelynek hatóanyaga a vékonybélben szabadul fel, nyugtató hatású. A kamilla, a levendulaolaj, a koriander, a citromfű és a kálmos szintén nyugtató hatással vannak a gyomorra és a belekre. Az említett növények teakészítményként kaphatók a gyógyszertárban. A papaya gyümölcséből készült különleges, organikusan előállított készítmények ellensúlyozzák az olyan panaszokat, mint a puffadás, a székeléskor jelentkező fájdalmat a székrekedést, illetve emellett nyugtatják a feszült emésztőrendszert is.
Kemény széklet esetén, rostban gazdag ételekkel érdemes óvatosan próbálkozni. Legyen ugyanakkor elővigyázatos és türelmes, ugyanis az élelmi rostok puffasztó hatásúak lehetnek. Az olyan nyálkaanyagok, mint a lenmag, az indiai psyllium és a búzakorpa növelik a bélmotilitását székrekedés esetén, sok vizet kötnek meg, ezáltal csökkentik a hasmenést is. Élelmiszerek, mint a rizs, a burgonya és a zab székrekedést okozhatnak. A puffadás ellen jótékonyan hathatnak a köményből, az édesköményből és ánizsból készült teaák, készítmények.
Probiotikum irritábilis bél szindróma esetén
Az irritábilis bél szindróma különböző okainak hatékony ellensúlyozására azonban vannak kíméletes módszerek, amelyek leküzdik az irritábilis bél szindróma okait, és megelőzik a tüneteket is: természetes bélbaktériumok – orvosok által alkalmazott probiotikus baktériumkészítmények – melyek alkalmazását a tudományos bizottságok és egyesületek az irritábilis bél szindróma minden tünetén ajánlják. Ezek a probiotikus bélbaktériumok nemcsak az irritábilis bélszindróma tüneteit, hanem annak okait is megszüntetik. Különböző módon képesek helyreállítani a bél egyensúlyát:
- A bélbaktériumok teljesen természetes mikroorganizmusok, melyek az egészséges bélrendszerben fordulnak elő, és számos módon támogatják emésztésünket és jó közérzetünket.
- A bélbaktériumok nem rendelkeznek nemkívánatos mellékhatással. A kezelés megkezdésekor időnként puffadás és székletváltozás jelentkezhet Ez azonban csak átmeneti, mielőtt a gyógyító hatás beindul.
- Bélbaktériumokkal (beleértve a bifidobaktériumokat, lactobacillusokat, lactococcusokat, streptococcusokat), melyeket a különböző kiváltó okok ellen speciális összetételben kombinálnak, gyulladás, áteresztő bél szindróma, káros baktériumok (gyakran antibiotikus kezelés vagy bélfertőzés után), motilitási zavarok, a panaszok okainak gyökeréhez jut és szünteti meg azokat.

A probiotikumok rendszeres alkalmazása erősíti a bélnyálkahártyát és annak barrier funkcióját, valamint a gyulladásos folyamatok megelőzését vagy leállítását.
Christoph Högenauer tudós számára ez a megközelítés pontosan megfelel a korábbi tanulmányi eredményeknek: „A közelmúltban megjelent 35 releváns tanulmány metaanalízise azt mutatja, hogy nem minden probiotikum egyformán hatékony. A tünetektől függően azonban összességében rendkívül pozitív hatást fejtenek ki. A legtöbb vizsgálat alapján a több fajból származó probiotikumok hatékonyabban enyhítik a kínzó tüneteket, mint az egyfajúak.” A tanulmányok összegzése szerint például az érintettek 21 százalékánál javultak a tipikus tünetek, 25 százalékuknál kevesebb hasi fájdalom, puffadás jelentkezett; a rettegett, sürgető székelési inger gyakorisága is jelentősen csökkent.
A Grazi Orvostudományi Egyetem új tanulmánya a probiotikumok irritábilis bél szindrómára gyakorolt hatására összpontosított. A hangsúlyt a bélnyálkahártya immunrendszerére helyezték (más néven mukózális immunrendszer), valamint arra, hogy a gyulladásgátló baktériumtörzsek hogyan támogatják a bélrendszert a stresszel kapcsolatos rendellenességek szabályozásában. Az eredmény a következő lett. A szinbiotikum rendszeres bevitele elősegíti a bélnyálkahártya és annak barrier funkciójának erősítését, valamint a gyulladásos folyamatok megelőzését vagy leállítását. Így a boldogság neurotranszmittere, a szerotonin és az alváshormon, azaz melatonin ismét elegendő mennyiségben képesek képződni, a belek pedig nyugalomba kerülhetnek. Mindeközben a Német Gasztroenterológiai, Emésztőrendszeri és Metabolikus Betegségek Társaságának (DGVS) iránymutatójában is javasolják probiotikumok bevitelétirritábilis bél szindróma esetén, a baktériumtörzsek kiválasztása a tünetek figyelembevételével javasolt. A DGSV az irritábilis bél szindrómával összefüggő fájdalom, hasmenés, székrekedés és puffadás esetén is javasolja a probiotikumok alkalmazását.

Tippek irritábilis bél szindróma esetén?
1. Tipp
Szánjon időt a kikapcsolódásra! Ha ellazul, azt belei is érzik! A stressz fokozza az irritábilis bél szindróma tüneteit. Az ellazulás és a rendszeres testmozgás visszaáálítja a belek egyensúlyát. Hasznos a szauna, a szabadtéri testmozgás és a vízi aktivitások. A relaxációs módszerek (pl. autogén tréning, jóga) gyakorlása segít a stressz, az idegesség és a szorongás tüneteinek kontrollálásában. A súlyos mentális egészségügyi problémákkal és depresszióval küzdő betegeknek javasolt pszichoterapeutához fordulniuk.
2. Tipp
Távolítsa el étrendjéből a puffasztó hatású, nehezen emészthető ételeket. Ehhez hasznosnak bizonyul egy táplálkozási napló vezetése, javasolt azokat az ételeket, italokat és helyzeteket azonosítani, melyek befolyásolják a tüneteket és kényelmetlenséget okoznak. A megelőzés jobb mint az orvoslás. Erősen ajánlott az irritábilis bél szindróma kiváltó okának kezelése! Bélmozgást serkentő rost alkalmazása esetén javasolt a vízben oldódó rostok (szentjánoskenyérgumi, pektin) fogyasztása. Egyen többször kevesebbet, rágja meg az ételt alaposan! Igyon eleget (pl. szénsavmentes ásványvizet)! Kerülje a zsíros és puffasztó ételeket, valamint a nagyon hideg és a túl forró italokat! A szénsavas üdítők és a gyümölcsök is gyakran okoznak kellemetlenséget.
Étkezzen rendszeresen, meghatározott időpontokban!
3. Tipp
Hagyjon fel a dohányzással, és alkoholt is csak mértékkel fogyasszon!
4. Tipp
A bélnyálkahártyát védő és az emésztési funkciókat egyensúlyban tartó probiotikus többfajú szinbiotikumok (akár hosszú távú) szedése ideális az IBS megelőzésére és kezelésére.